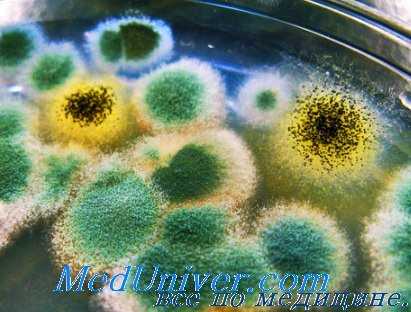
антибиотикотерапия

Проникновение пенициллина через гематоэнцефалический барьер. Интракаротидный метод антибиотикотерапии
Добавил пользователь Skiper Обновлено: 12.12.2025
Ученые утверждают, что бактерии существуют на Земле как минимум 3,8х10 9 лет, в то время как антибиотики используются в клинической практике лишь с 40‑х годов прошлого века [1]. Но и этого времени хватило, чтобы препараты указанной группы обросли множеством мифов, которые мешают эффективной антибиотикотерапии. Несмотря на то что лечение антимикробными средствами априори невозможно без непосредственного руководства врача, современный «пациент разумный», подверженный влиянию околонаучных данных, вносит свой «неоценимый вклад» в дело антибиотикорезистентности и прочих негативных последствий некорректного применения антибиотиков. Предостеречь его от опрометчивых решений может грамотный фармспециалист, который владеет корректной информацией об антимикробных средствах и готов поделиться ею с клиентом.
Миф. Современные антибиотики настолько «сильные», что перед ними не устоит ни одна бактерия
- Изначально устойчивые штаммы. Например, некоторые грамотрицательные бактерии имеют наружные клеточные мембраны, защищающие их клетки от действия ряда пенициллинов и цефалоспоринов.
- Спонтанные мутации, приводящие к появлению организмов, устойчивых к антибиотикам.
- Передача генов устойчивости к антимикробным препаратам — самый распространенный и важный механизм развития антибиотикорезистентности.
Устойчивость к антибиотикам — глобальная проблема, которая может иметь непредсказуемые последствия для каждого из нас. Увы, но огромный вклад в ее существование вносят сами потребители. Об этом уместно напомнить покупателям с рецептами на антибиотики, подчеркнув, что существенно снизить риски развития устойчивых штаммов позволяет прием антимикробных препаратов только по назначению врача и четкое соблюдение дозы и режима антибиотикотерапии.
Миф. Чтобы вылечиться побыстрее, нужны «сильные» антибиотики широкого спектра действия
- Установка диагноза настолько точная, насколько это возможно. Знание диагноза позволяет определить предполагаемого возбудителя.
- Определение возбудителя, если это возможно.
- Принятие взвешенного решения о необходимости назначения антибиотиков.
- Подбор оптимального антибиотика с учетом фармакокинетики и спектра активности.
- Подбор оптимальной дозы и курса лечения (последний при большинстве острых инфекций должен составлять не менее 5–10 дней).
- Контроль эффективности антибиотикотерапии.
В российских реалиях, когда контроль за приемом антибиотиков, откровенно говоря, недостаточен, особенно остро стоит вопрос некорректного подбора препаратов. Известно, что его осуществляют двумя способами: этиотропным и эмпирическим. В первом случае антибиотик применяется целенаправленно против определенного, точно установленного возбудителя. Без сомнения, это рационально и оправданно. Однако идентификация микроорганизма, вызвавшего инфекцию, требует времени, обычно это занимает несколько суток. Когда процесс протекает остро и больному требуется немедленная помощь, выделение возбудителя — неоправданная роскошь. В такой ситуации назначают эмпирическую терапию, подбирая препарат с учетом наиболее вероятных возбудителей [3]. Например, самый частый возбудитель пневмонии — пневмококк, цистита — кишечная палочка и так далее.
Если антибиотик был подобран корректно и все остальные принципы антибиотикотерапии были соблюдены, он, без сомнения, окажется «сильным». А вот тот же препарат, применяемый неправильно (независимо от того, на каком этапе была сделана ошибка), может проявить «слабость» и не оказать терапевтического действия.
Миф. Хотя многие сульфаниламидные препараты почти ушли в прошлое, ко-тримоксазол по‑прежнему сохраняет свои позиции в ряду антимикробных препаратов
Правда. Сульфаниламиды стали первыми эффективными химиотерапевтическими средствами, успешно применяемыми для профилактики и лечения бактериальных инфекций. И хотя область их применения значительно сузилась с появлением пенициллина, а позже и других антибиотиков, некоторые их представители длительное время занимали нишу в ряду антимикробных препаратов. Речь в первую очередь идет о синергической комбинации триметоприма и сульфаметоксазола, известной под МНН ко-тримоксазол.
Ко-тримоксазол представляет собой мощный селективный ингибитор микробной дигидрофолатредуктазы — фермента, восстанавливающего дигидрофолат до тетрагидрофолата. Блокирование этой реакции обеспечивает нарушение образования пуриновых и пиримидиновых оснований, нуклеиновых кислот и таким образом подавляет рост и размножение микроорганизмов [4]. Однако в последние годы резко увеличилось количество штаммов бактерий, резистентных к ко-тримоксазолу, и распространенность устойчивости продолжает быстро нарастать.
Предполагается, что ранее чувствительные к препарату микроорганизмы в ходе эволюции приобрели внехромосомные молекулы ДНК (плазмиды), которые кодируют измененную дигидрофолатредуктазу. Благодаря им устойчивость к ко-тримоксазолу формируется практически у каждого третьего изолята кишечной палочки в моче [4]. Ситуация с остальными штаммами ранее чувствительных к препарату бактерий ненамного лучше. В связи с этим сегодня применение ко-тримоксазола резко ограничено, и препарат практически уступил место более эффективным и безопасным антимикробным препаратам [5].
Миф. Пероральные цефалоспорины такие же «сильные», как и парентеральные
Цефалоспорины (ЦС) — один из самых обширных классов антимикробных препаратов, представленных как в пероральной, так и парентеральной форме. При этом выраженность антибактериального эффекта в первую очередь определяется принадлежностью к одному из четырех поколений. Антибиотики цефалоспорины 1 поколения — парентеральный цефазолин и пероральный цефалексин — имеют самый узкий спектр активности, схожий со спектром аминопенициллинов (ампициллина, амоксициллина) [3]. Цефалоспорины II поколения (парентеральный цефуроксим, пероральный цефаклор) активны в отношении грамотрицательных бактерий, при этом по действию на стафилококки и стрептококки они близки к предшественникам. Таким образом, мощность представителей антибиотиков первого и второго поколений практически не зависит от лекарственной формы. Но с цефалоспоринами последующих поколений всё не так просто.
Известно, что антибиотики 3 поколения обладают более высокой по сравнению с ЦС-I и ЦС-II активностью в отношении грамотрицательных бактерий, пневмококков и стрептококков. Однако их пероральные формы цефиксим и цефтибутен определенно обладают более узким спектром активности, чем парентеральные цефтриаксон, цефтазидим и цефоперазон. В частности, препараты для приема внутрь не действуют в отношении пенициллинорезистентных пневмококков, что связывают с их относительно невысокой биодоступностью. Так, биодоступность цефиксима составляет всего 40–50 %, в то время как у парентеральных форм она приближается к 100 % [3].
Тем не менее, цефиксим считается мощным антибиотиком, применение которого оправдано при инфекциях мочевыводящих путей, а также среднем отите и фарингите. Цефтибутен применяют гораздо реже: он показан только для терапии острых бактериальных осложнений хронического бронхита, среднего отита, фарингита и тонзиллита. Существенный недостаток этого препарата — низкая активность в отношении золотистого стафилококка [4]. В то же время парентеральные цефалоспорины третьего поколения широко применяются для лечения тяжелых инфекций верхних, нижних дыхательных путей, желчевыводящих путей, мягких тканей, кишечных инфекций, сепсиса и других [3].
Миф. Хлорамфеникол — «сильный» безопасный антибиотик при кишечных инфекциях
Правда. С одной стороны, хлорамфеникол действительно имеет широкий спектр активности, включающий грамположительные и грамотрицательные кокки, грамотрицательные палочки, в том числе кишечную и гемофильную, а также других возбудителей кишечных инфекций — сальмонелл, шигелл и так далее. Но, с другой стороны, препарат связан с не менее широким спектром неблагоприятных реакций.
Известно, что хлорамфеникол угнетает кроветворение, вызывая тромбоцитопению, анемию и даже фатальную апластическую анемию (хотя и всего в 1 случае на 10 000–40 000 пациентов) [3]. Кроме того, он оказывает гепатотоксическое, нейротоксическое действие и проявляет другие побочные эффекты. Ввиду крайне неблагоприятного профиля безопасности хлорамфеникол считается антибиотиком резерва и назначается исключительно в случаях, когда польза от его применения превышает риск побочных эффектов. Это происходит, как правило, если по каким‑то причинам не удается подобрать другой препарат антибактериального действия [3, 5].
Миф. Тетрациклины традиционно «слабые» антибиотики, значительно менее мощные, чем пенициллины
Правда. На самом деле тетрациклины имеют широкий спектр антибактериальной активности, причем современные их представители действуют в отношении еще большего количества бактерий, чем их предшественники, включая ряд возбудителей, устойчивых к другим классам антибиотиков. Так, тигециклин, появившийся на рынке только в середине 2000‑х, был разработан в рамках программы по борьбе с растущей антибиотикорезистентностью таких «сложных» в этом плане возбудителей, как золотистый стафилококк и кишечная палочка [6].
Тетрациклины, в том числе и применяемые на протяжении десятилетий тетрациклин и доксициклин, способны проникать внутрь клетки, поэтому они и сегодня широко применяются для лечения внутриклеточных инфекций, передающихся половым путем (хламидиоза, уреаплазмоза, микоплазмоза). К показаниям к их назначению относится и хеликобактерная инфекция — в составе эрадикационной терапии. Благодаря эффективности в отношении Propionibacterium acne тетрациклины наряду с макролидами применяются для лечения угревой болезни. Миноциклин, чей спектр включает Neisseria meningitidis, используется для профилактики менингококковой инфекции [2].
В качестве ложки дегтя следует упомянуть и о том, что для большинства тетрациклинов (за исключением современных представителей) свойственны высокий уровень вторичной резистентности многих бактерий и к тому же перекрестная устойчивость микроорганизмов [3]. И это, несомненно, во многих случаях снижает их актуальность.
Миф. Фторхинолоны — слишком «сильные» антибактериальные ЛС, поэтому их не применяют для лечения детей
Правда. Фторхинолоны — обширная группа антимикробных препаратов, включающая представителей четырех поколений. Сегодня используются хинолоны последних трех поколений, причем наибольшей активностью обладают антибиотики, принадлежащие к III (левофлоксацин, спарфлоксацин, гатифлоксацин) и IV (моксифлоксацин, клинафлоксацин) поколениям. Их спектр активности включает пневмококков, в том числе пенициллинорезистентных, атипичных возбудителей (хламидии, микоплазмы), большинство грамотрицательных бактерий, стрептококков, анаэробов и другие. К безусловным преимуществам современных хинолонов относятся устойчивость к бета-лактамазам, медленное развитие резистентных штаммов, высокая биодоступность пероральных форм препаратов, низкая токсичность, а также длительность действия, позволяющая назначать многие препараты 1 раз в сутки [7].
Фторхинолоны являются препаратами выбора при инфекциях мочевыводящих, желчевыводящих, дыхательных путей, инфекциях, передаваемых половым путем, гинекологических заболеваниях и так далее [7]. Но при всех своих преимуществах фторхинолоны имеют и ряд недостатков, среди которых возможность поражения хрящевых точек роста костей у детей. Впрочем, этот эффект был выявлен во время токсикологических исследований на неполовозрелых животных. Согласно клиническим данным, общее число побочных эффектов фторхинолонов — как по количеству, так и по качеству — у детей и взрослых не отличается [8]. Более того — во всем мире распространена практика использования антибактериальных этой группы у детей [9], хотя в России возраст до 18 лет по‑прежнему остается противопоказанием к их применению.
Миф. Эритромицин — «слабый» макролид, намного уступающий современным представителям этого класса препаратов
Правда. Эритромицин, так же как и другие макролиды, обратимо связывается с 50S субъединицей рибосом, нарушая процесс транслокации и образования пептидных связей между молекулами аминокислот и блокируя синтез белков чувствительных бактерий. Несмотря на существование современных представителей класса — азитромицина, кларитромицина и других, — эритромицин по‑прежнему считается препаратом выбора для лечения ряда инфекций, в частности, микоплазменной инфекции у детей, легионеллеза, дифтерии и коклюша [2].
Наряду с высокой активностью, эритромицин выделяется недостаточно хорошей переносимостью. Известно, что у 30–35 % пациентов он вызывает диспепсию, а также имеет ряд других побочных эффектов [3]. В связи с этим на практике нередко отдают предпочтение современным представителям этой группы.
Миф. Амоксициллин такой же сильный антибиотик, как амокисициллина клавуланат – по сути, это один и тот же препарат
Правда. Амоксициллин наряду с ампициллином относится к аминопенициллинам расширенного спектра, действующим в отношении грамположительных и грамотрицательных бактерий. Он и сегодня считается самым активным среди всех пероральных лактамных антибиотиков в отношении пенициллин-чувствительных и пенициллин-резистентных пневмонийных стафилококков [4]. Однако нельзя не учитывать, что ряд бактерий выработали устойчивость к пенициллинам и аминопенициллинам в частности. Так, широко распространены устойчивые штаммы гемофильной палочки, пневмококка, энтеробактерий. Выходом из этой ситуации является применение ингибиторозащищенных аминопенициллинов, таких как амоксициллин/клавуланат и ампициллин/сульбактам, устойчивых к действию бета-лактамаз и имеющих, соответственно, более широкий спектр активности [4].
Таким образом, назначение аминопенициллинов обосновано при легких и неосложненных инфекциях, в то время как при тяжелых и рецидивирующих формах показаны ингибиторозащищенные препараты. При этом путь введения (парентеральный или пероральный) выбирают в зависимости от тяжести инфекции [3].
Проникновение пенициллина через гематоэнцефалический барьер. Интракаротидный метод антибиотикотерапии
Комбинированное лечение отогенного менингита. Эффективные комбинации антибиотиков в прошлом
В лечении отогенного менингита наиболее эффективным оказывается комбинированное применение пенициллина со стрептомицином. Такое сочетание антибиотиков значительно расширяет диапазон их действия. Стрептомицин обладает более широким антибактериальным спектром, нежели пенициллин. Пенициллин действует в основном на грамположительную флору, в то время как стрептомицин действует и на грамотрицатель-ную. Поэтому стрептомицин находит применение при ряде инфекционных заболеваний, на которые не оказывают эффекта другие антибиотики.
Комбинированный способ лечения пенициллином и стрептомицином особенно показан в тяжелых случаях менингита. Применение обоих антибиотиков при менингите очень важно. Один антибиотик усиливает антибактериальные свойства другого и в итоге совместного действия они дают большой терапевтический эффект. Кроме того, одновременное применение указанных антибиотиков предотвращает возможность образования резистентных к действию каждого из них в отдельности микроорганизмов. Такой способ лечения значительно сокращает период болезни, делает его более коротким, приводит к быстрому снижению явлений интоксикации.
Методика лечения пенициллином и стрептомицином установлена эмпирически. Она состоит в введении пенициллина в количестве 800 тыс. — 1 млн. ЕД в сутки, а стрептомицина 0,5—1 млн. ЕД. Указанные препараты вводятся внутримышечно: пенициллин через каждые 3 к, а стрептомицин в зависимости от его дозировки 1 или 2 раза в день. Детям до 3 лет стрептомицин назначается по 200—250 тыс. ЕД в сутки, от 4 до 7 лет — по 250—300 тыс. ЕД в сутки, от 8 лет и старше по 300— 500 тыс. ЕД в сутки.
Если при пенициллинотерапии длительность лечения, по нашим данным, равняется в среднем 8—12 дням, то комбинированное применение пенициллина и стрептомицина при менингите ликвидирует болезненный процесс приблизительно в течение 4—8 дней.
Эффективна также, по нашим наблюдениям, комбинированная терапия менингита стрептомицином или пенициллином в сочетании с каким-нибудь антибиотиком группы тетрациклинов.

Действие биомицина и тетрациклина распространяется как на грамположительную, так и на грамотрица-тельную флору. При комбинированном применении упомянутых антибиотиков стрептомицин и пенициллин вводятся внутримышечно в дозировке, указанной нами выше, а биомицин внутрь 4 раза в день по 200 тыс. ЕД. Суточная доза биомицина для взрослого человека равна приблизительно 800 тыс.— 1 млн. ЕД. Для детей биомицин назначается из расчета 25 тыс. ЕД на 1 кг веса в сутки. Результаты лечения отогенного менингита двумя или тремя антибиотиками благоприятны. Они дают хороший терапевтический эффект и приводят к быстрому излечению заболевания.
Однако назначение биомицина не всегда возможно. В тех случаях, когда менингит сопровождается тошнотой и особенно рвотой, его применение нецелесообразно. Пероральное введение его усиливает указанные явления.
Тетрациклин вводится перорально или внутримышечно. Взрослым больным он вводится по 100 тыс. ЕД, а детям до 1 года— 10 тыс. ЕД, от 1 до 5 лет — 20 тыс. ЕД, старше 5 лет — 30 тыс. ЕД. Тетрациклин вводится 2—3 раза в сутки. После 5—7 дней применения делается перерыв на 4—7 дней.
Лечение антибиотиками должно быть динамичным в том смысле, что если назначенный антибиотик не дает эффекта, то он должен быть заменен другим.
Если комбинированное лечение антибиотиками оказывается неэффективным, то нужно изменить их сочетание.
Отсутствие эффекта от антибиотикотерапии указывает на резистентность флоры, вызвавшей отогенный менингит, к действию назначенных антибиотических веществ. Поэтому важно определить чувствительность флоры патологического содержимого уха к различным антибиотикам или еще лучше (где это возможно) возбудителя, выделенного из спинномозговой жидкости. Не ожидая результатов упомянутых исследований, лечение больных отогенным менингитом должно начинаться с момента установления диагноза заболевания.
Эффективность лечения отогенного менингита зависит от многих факторов: 1) давности заболевания и времени начала лечения, 2) особенности течения болезни, 3) сочетания менингита с другими внутричерепными осложнениями и т. п.
Информация на сайте подлежит консультации лечащим врачом и не заменяет очной консультации с ним.
См. подробнее в пользовательском соглашении.
Вопрос о попадании пенициллина в цереброспинальную жидкость при разных способах его введения в организм изучался многими авторами как экспериментально, так и клинически. В. К. Супрунов, В. В. Кованов и др. изучали всасывание и распределение пенициллина в спинномозговой жидкости. Оказалось, что пенициллин, введенный разными способами больным, страдавшим менингитом, определялся ими в заметной концентрации в ликворе. Это объясняется тем, что при менингите повышается проницаемость гемато-энцефалического барьера по отношению к лекарственным веществам, содержащимся в крови, и в том числе для пенициллина.
Отсюда они приходят к выводу, что нет надобности пользоваться многими способами введения пенициллина, что достаточно применить один внутримышечный способ для воздействия на менингеальный процесс.
Гемато-энцефалический барьер является одним из многих приспособлений, которым организм ограждает себя от вредных воздействий внешней среды. Гематоэнцефалический барьер выполняет сложную функцию, регулируемую нервной системой. В норме он не проницаем для многих лекарственных и токсических веществ. Это имеет большое значение для функций центральной нервной системы. При воспалении мозговых оболочек гемато-энцефалический барьер становится проницаем для пенициллина. Попадая в полость черепа, антибиотик оказывает благоприятное действие на патологический процесс.
Интересные данные приводит Расмуссен (Rasmussen). Он суммирует результаты лечения 203 больных менингитом. Смертность для всей группы больных равняется 20,7%. Сравнивая результаты лечения, полученные при одном внутримышечном введении пенициллина, с теми, которые получены при внутримышечном и интралюмбальном, автор указывает, что смертность в обеих группах больных приблизительно одинаковая. На основании этого автор делает осторожный вывод, что введение пенициллина в субарахноидалыюе пространство не показано.
В. И. Покровский, Фейбуш, Мурфи и Любарт, Бунн и Пибоди, Хара (Feibush, Murphy и Lubart, Bunn и Peabody, Нага), Долмен и Гольмгрен на основании своих наблюдений прямо говорят, что при внутримышечном введении больших доз антибиотика интралюмбальное его применение отпадает. Мы подробно остановились на этом вопросе, так как он имеет принципиально важное значение.

Интракаротидный метод антибиотикотерапии
Этот способ введения лекарственных веществ при черепномозговых ранениях, осложненных инфекцией, предложен Н. Н. Бурденко в 1942 г. Вначале он применял растворы сульфаниламидов, а в 1946 г. предложил введение пенициллина в сонную артерию. Метод лечения состоял в следующем: в сонную артерию вводится 10 тыс. ЕД пенциллина и 40 тыс. ЕД внутримышечно. Одновременно с этим внутривенно вводится 10 мл 10%-го раствора хлористого натрия, назначается диета — сухоядение. Такое комбинированное введение пенициллина производится 1 раз в сутки и этого достаточно для поддержания его концентрации на относительно высоком уровне (0,1 ЕД в 1 мл крови).
Н. М. Арбузов, пользовался комплексным методом введения пенциллина при отогенном менингите. Наряду с внутримышечным и эидолюмбальным способами введения пенициллина, он также вводил его внутриартери-ально. Он считает, что такой комбинированный метод введения пенициллина при тяжелых отогенных осложнениях является наиболее эффективным.
Этот автор детально изучил интракаротидный метод введения пенициллина. Из осложнений, возникающих при пользовании им, он отмечает познабливание, часто сопровождающееся повышением температуры. Им наблюдался тромбоз средней мозговой артерии, наступивший после инъекции пенициллина в сонную артерию. Случай закончился выздоровлением, но с неполным восстановлением функции левой верхней конечности. Арбузов считает, что этот метод лечения нуждается в совершенствовании, дабы предупредить возможность осложнений или свести их к минимуму.
С целью избежания общих реакций организма, а также предупреждения эмболии сосудов мозга сгустками крови, образующимися в шприце при попадании крови в раствор пенициллина, он рекомендует вводить небольшие дозы пенициллина внутриартериально (по 5—10 тыс. ЕД на 0,5 — 1%-ном растворе гепарина) и притом медленно. Разумеется, метод лечения, дающий сам по себе те или иные осложнения и представляющий известные трудности технического порядка, не может найти широкого применения. Он может быть использован лишь в исключительных случаях и то при наличии определенных показаний. Что касается благоприятных результатов, полученных им при лечении больных отогенным менингитом (из 24 больных выздоровело 23), то они все-таки недостаточно убедительны, так как пенициллин вводился больным одновременно внутримышечно и интракаротидно, причем интракаротидно небольшими дозами в 5—10 тыс. ЕД.
Такой большой процент выздоровления может быть объяснен только тем, что автор, очевидно, имел дело с «чистыми» формами менингита, не осложненного другими внутричерепными заболеваниями.
Фармакокинетика пероральных антимикробных препаратов
Абсорбция, распределение и элиминация лекарственного средства тесно связаны с его фармакологическими свойствами и побочными реакциями. Именно поэтому особенности фармакокинетики — предмет пристального интереса как ученых, так и практикующих специалистов. И первостольникам, играющим роль связующего звена между фармацевтической промышленностью, врачом и потребителями, важно помнить, как всасываются и выводятся препараты, включая те, которые отпускаются по рецепту. К тому же разъяснять покупателям особенности приема лекарственных средств, рассказывать о противопоказаниях и побочных эффектах — прямая задача фармспециалиста. И сегодня мы поговорим о фармакокинетике одного из самых обширных и востребованных классов лекарственных препаратов — антибактериальных средств.

Следуя инструкции: общая информация
Прежде всего, рассмотрим самые важные фармакокинетические термины, которые используются в основном в отношении антимикробных средств и часто упоминаются в инструкциях по их применению.
Минимальная ингибирующая концентрация (МИК) представляет собой минимальную концентрацию препарата, которая будет блокировать рост патогенного микроорганизма. Очевидно, что содержание антибиотика в инфицированных тканях должно быть выше, чем МИК. И если препарат А имеет более низкую МИК, чем препарат В, то первый будет убивать возбудителя при более низкой концентрации и, следовательно, проявлять более мощный антибактериальный эффект. Разумеется, при условии, что остальные факторы идентичны [1].
Если уровень МИК препарата для конкретного патогена является низким, последний считается чувствительным к антибиотику. При умеренных значениях МИК чувствительность является промежуточной, а при высоких она отсутствует вовсе, и возбудитель считается устойчивым по отношению к антимикробному средству [1].
Время, в течение которого концентрация препарата в тканях превышает величину МИК (часто обозначается как Т). Антибиотики некоторых групп, в частности, бета-лактамы (ампициллин, амоксициллин и макролиды, за исключением азитромицина) считаются «время-зависимыми» препаратами. Их эффективность определяет концентрация в крови, которая выявляется в течение 40–50 % от длительности интервала дозирования (как правило, около 5–6 часов) [2]. Можно сказать, что эффективность антибиотиков этой категории зависит от продолжительности действия. Чтобы они работали хорошо, их МИК должна быть постоянно превышена.
При уменьшении рекомендуемой кратности приема время-зависимых антибиотиков их эффективность резко снижается [3].
Отношение Сmax/МИК — максимальная концентрация антибиотика по сравнению с МИК. Некоторые антибиотики работают только при условии очень высокой максимальной концентрации. Они называются концентрационно -зависимыми. К препаратам этой группы относятся аминогликозиды (канамицин, гентамицин).
Отношение AUC/МИК — еще один параметр, который часто встречается в инструкциях по применению. Он отражает отношение величины площади под кривой «время-концентрация» (AUC, от англ. аrea under curve) к минимальной ингибирующей концентрации. Считается, что именно AUC/МИК является основным фармакокинетическим параметром эффективности. Препараты, мощность которых определяется как продолжительностью действия, так и концентрацией, — фторхинолоны и тетрациклины [3].
Ну а теперь, вспомнив основные фармакокинетические термины, перейдем к особенностям абсорбции, распределения и выведения современных пероральных антибактериальных ЛС различных групп.
Пенициллины
Основным современным представителем пероральных пенициллинов является амоксициллин. Его наиболее характерные фармакокинетические свойства [1–4]:
- Сохраняет активность в очаге воспаления (при низком pH, высокой концентрации лейкоцитов, белка);
- Хорошо всасывается из ЖКТ, что объясняет эффективность пероральной формы: абсорбция составляет 75–93 %;
- Биодоступность не зависит от пищи, то есть можно применять и до, и после еды;
- В небольшом количестве проникает в грудное молоко, однако не оказывает негативного действия на младенцев (за исключением риска сенсибилизации, диареи и кандидоза слизистой полости рта);
- Проникает через плацентарный барьер, но не оказывает негативного влияния на плод и фертильность. Безопасен при беременности, поэтому широко применяется в этот период, «если потенциальная польза для матери превышает потенциальный риск для плода»;
- Плохо проникает через гематоэнцефалический барьер;
- Как и все пенициллины, очень быстро выводится почками.
Цефалоспорины
Фармакокинетика пероральных и парентеральных цефалоспоринов значительно отличается, что во многом определяет и свойства препаратов, и их показания.
Пероральные цефалоспорины всасываются быстро и хорошо, однако их биодоступность может быть очень разной. Так, биодоступность цефиксима (III поколение) составляет всего 40–50 %. Гораздо более высокие показатели у представителей I и II поколений, таких как цефалексин и цефаклор — до 95 %.
Препаратам этой группы для приема внутрь также свойственны следующие фармакокинетические параметры [1–4]:
- Замедление скорости всасывания при одновременном приеме с пищей (однако на биодоступность пища не влияет);
- Способность проникать через гематоэнцефалический барьер (для III поколения), позволяющая применять препараты этой группы для лечения менингита;
- Отсутствие метаболизма — большинство цефалоспоринов выделяются почками в неизменном виде. Поскольку препараты выводятся почками, при нарушении их работы дозу цефалоспоринов снижают;
- Низкая скорость полувыведения — у большинства цефалоспориновых антибиотиков она составляет 1–2 часа, что определяет необходимость их назначения 3–4 раза в сутки. Исключением являются представители III поколения цефиксим и цефтибутен, которые применяют 1 раз в сутки.
Макролиды
Несмотря на то, что все макролиды в основе своей химической структуры имеют макроциклическое лактонное кольцо, их свойства, в том числе и фармакокинетические, значительно разнятся. Особенно выделяется в ряду макролидов азитромицин, содержащий дополнительно молекулу азота в макролидном кольце, что придает последнему повышенную устойчивость [1–4]. Ключевые фармакокинетические свойства марколидов:
- Быстро всасываются из ЖКТ;
- Имеют невысокую биодоступность: кларитромицин и рокситромицин — 50 %, азитромицин — 37 %. Для последнего характерен эффект «первого прохождения» через печень — препарат частично инактивируется еще до поступления в системный кровоток;
- На всасывание некоторых макролидов влияет пища: она существенно снижает биодоступность эритромицина, в меньшей степени азитромицина и практически не влияет на биодоступность кларитромицина и спирамицина, хотя и замедляет их абсорбцию;
- Эритромицин нестабилен в солянокислой среде желудка, поэтому должен вводиться в составе солей, сложных эфиров или в форме таблеток с кишечнорастворимой оболочкой;
- Добавление метильной группы к эритромицину приводит к образованию кларитромицина, а присоединение к тому же эритромицину метилированного азота позволяет получить азитромицин. И кларитромицин, и азитромицин стабильны в солянокислой среде желудка и очень хорошо всасываются при пероральном применении;
- Период полувыведения эритромицина, кларитромицина и азитромицина составляет, соответственно, 1,5 часа, 6 часов и 68 часов. Таким образом, кратность применения эритромицина составляет 4 раза в день, кларитромицина — 2 раза в день, а азитромицина — 1 раз в день. При назначении кларитромицина в больших дозах возможно его применение 1 раз в день;
- Из-за большой продолжительности действия азитромицина 5‑дневный пероральный курс лечения с кратностью применения 1 раз в день считается адекватным при большинстве чувствительных к антибиотику инфекций;
- Все макролиды хорошо проникают в органы и ткани и считаются тканевыми антибиотиками. Пиковая концентрация в сыворотке крови намного ниже, чем в тканях (миндалины, придаточные пазухи носа, легкие, предстательная железа);
- Макролиды проникают внутрь клеток, создавая там высокие концентрации, что позволяет применять их для лечения внутриклеточных инфекций;
- Макролиды не проникают в спинномозговую жидкость. Поэтому их не применяют для лечения инфекций нервной системы;
- Проникают через плаценту и экскретируются в грудное молоко;
- Эритромицин и кларитромицин — важные ингибиторы фермента CYP450. При совместном применении с препаратами, метаболизирующимися в печени при участии ферментов цитохрома P450 (варфарин, другие непрямые антикоагулянты, карбамазепин, теофиллин, циклоспорин, алкалоиды спорыньи и другие), может усиливать эффект последних;
- Азитромицин не является ингибитором ферментов CYP450 и, соответственно, не вступает в лекарственные взаимодействия с препаратами, метаболизирующимися изоферментами цитохрома Р450;
- Выделяются с желчью;
- При почечной недостаточности период полувыведения не меняется, при печеночной — значительно увеличивается. Следовательно, в первом случае терапевтические дозы не корректируются, а во втором — снижаются.
Фторхинолоны
Все хинолоны имеют ряд общих фармакокинетических свойств [1–4]:
- Хорошо всасываются из ЖКТ и проникают в органы и ткани, создавая в них терапевтические концентрации. Пероральным формам отдается предпочтение перед парентеральными (при условии переносимости первых);
- Биодоступность может достигать 99 %;
- Наиболее высокие концентрации в тканях создаются при приеме офлоксацина и ломефлоксацина. Наименее высокие характерны для норфлоксацина;
- Пища может замедлять процесс всасывания из пищеварительного тракта, но не влияет на биодоступность фторхинолонов;
- Ципрофлоксацин, офлоксацин и пефлоксацин проникают через гематоэнцефалический барьер;
- Все фторхинолоны проникают внутрь клетки и применяются для лечения внутриклеточных инфекций;
- Большинство фторхинолонов выводятся почками, поэтому при нарушении их функций необходима корректировка дозы. Исключение составляет моксифлоксацин, который метаболизируется в печени и применяется при выраженной печеночной недостаточности с осторожностью.
Тетрациклины
Общие черты фармакокинетики препаратов этой группы выглядит следующим образом [1–4]:
- Биодоступность доксициклина составляет 90–100 % и практически не зависит от приема пищи, тетрациклина — 75 % натощак и около 37 % при приеме с пищей. Соответственно, тетрациклин нужно принимать натощак;
- Все тетрациклины связываются и инактивируются двухвалентными катионами, в том числе кальцием и магнием. Поэтому совместный прием антибиотиков этой группы и препаратов кальция или магния влияет на эффективность тетрациклинов. Чтобы избежать лекарственных взаимодействий, антимикробные препараты нужно принимать натощак;
- Распределяются во многих органах и тканях. Доксициклин по сравнению с тетрациклином создает более высокие тканевые концентрации;
- Проникают через плацентарный барьер и в грудное молоко в высоких концентрациях. Противопоказаны при беременности и лактации;
- Метаболизируются в печени;
- Тетрациклин выводится преимущественно почками, поэтому при почечной недостаточности необходима коррекция дозы. Доксициклин выводится почками и через ЖКТ, причем при поражении почек пищеварительный путь выведения становится основным;
- Период полувыведения доксициклина в два раза выше по сравнению с тетрациклином — 15–24 часа и 8 часов, соответственно.
Хлорамфеникол
Также отдельно стоит рассмотреть фармакокинетику хлорамфеникола [1–4]:
- Хлорамфеникол хорошо всасывается из пищеварительного тракта, биодоступность составляет 70–80 %;
- Всасываемость и биодоступность не зависит от приема пищи;
- Хорошо распределяется в организме, создавая высокие концентрации в бронхиальном секрете, желчи, а также в цереброспинальной жидкости и головном мозге даже при отсутствии менингиального воспаления;
- Проникает через гематоэнцефалический барьер;
- Выделяется через почки, причем в неактивном состоянии. Поэтому при почечной недостаточности необходимости в снижении дозы нет.
Итоги
В заключении хотелось бы подчеркнуть — фармакокинетика часто кажется областью сложной и запутанной. Однако на деле фармакокинетические свойства в пределах одного класса препаратов зачастую схожи, и, выстроив для себя стройный ряд «биодоступность-всасываемость-элиминация» для конкретной группы, можно научиться быстро и легко отвечать на вопросы посетителя о том, когда и как принимать тот или иной антибиотик. Главное — желание и настойчивость, а их провизорам и фармацевтам не занимать.
Резистентность к антибиотикотерапии. Эффективность пенициллина в лечении менингита в прошлом
Лабораторные исследования показали, что многие виды гнойной (стафилококки, стрептококки и т. п.) и другой инфекции при соответствующих условиях проявляют свою резистентность к действию антибиотических веществ. Попутно отметим, что среди микроорганизмов значительно легче развиваются формы, устойчивые более к стрептомицину, чем к пенициллину (Г. Ф. Гаузе). Таким образом, скорость повышения устойчивости микроорганизмов к стрептомицину выше, чем к пенициллину.
Сущность этого явления, т. е. появления устойчивых форм микроорганизмов, как полагает Г. Ф. Гаузе, заключается, по-видимому, в таком изменении обмена веществ у резистентных микроорганизмов, которое делает их неуязвимыми для антибиотиков. Это обстоятельство очень важно знать клиницистам, пользующимся антибиотиками.
Большие дозы пенциллина более эффективны, они быстро и полно проявляют свое антибактериальное действие, что очень важно при этом заболевании.
Механизму действия пенициллина посвящено много работ. Мы коснемся этого вопроса в кратких чертах, так как более подробное его изложение не входит в нашу задачу. Решающее значение в успехе пенициллинотерапии принадлежит состоянию макроорганизма. Эффективность лечения пенициллином зависит от реактивности целостного организма, от состояния его внутренней среды, регулируемой центральной нервной системой. Действие пенициллина разнообразно. Он обладает бактерицидным и бактериостатическим свойствами. Одним из важнейших свойств пенициллина, впрочем как и других антибиотиков, является способность его оказывать угнетающее влияние на жизнедеятельность различных патогенных возбудителей.
Под влиянием антибактериальных препаратов возбудители болезни перестают размножаться и оказываются на это время более уязвимыми для защитных реакций организма. Пенициллин обладает также антитоксическими свойствами. В пользу последнего говорит быстро наступающее улучшение общего состояния больного при лечении его пенициллином. Как показали лабораторные опыты И. Г. Руфанова А. В. Григорян, сам пенициллин не нейтрализует токсин, а усиливает нейтрализующий эффект крови. Пенициллин, действуя парализующим образом на патогенную флору, вызвавшую болезнь, усиливает защитные силы организма и ускоряет тем самым процессы выздоровления.
За последние годы появилась обширная литература, посвященная пенициллинотерапии отогенного менингита. Ее результаты изучаются многими клиницистами. Так, В. И. Воячек и В. Ф. Ундриц указывают, что процент выздоровления при отогенном менингите, леченном пенициллином, достигает 60. Многие авторы приводят другие данные, но все они свидетельствуют об эффективности лечения гнойного менингита антибиотиками.
Отдельные клинические наблюдения, касающиеся эффективности пенициллинотерапии отогенного менингита, опубликованы рядом авторов (И. С. Александрии, М. И. Гаршин, И. Ф. Герасимов, Т. М. Изакович, А. Г. Лихачев, М. Г. Тоборисский, В. В. Шестаков, Г.утчинсои, Шустер — Hutchinson, Shuster — и др.).
Лечение больных у вышеупомянутых авторов было комплексным. Причем некоторые из них применяли пенициллин комбинированно: внутримышечно и интралюмбально, внутримышечно и субокципитально, другие вводили пенициллин только внутримышечно. Большинство авторов проводило комбинированное лечение пенициллином и сульфаниламидными препаратами. Они при этом исходят из данных лабораторных исследований и клинических наблюдений, которые свидетельствуют о том, что действие пенициллина в присутствии сульфаниламидов усиливается. Дозы пенициллина, которыми пользовались авторы, различны.
Как видно, у некоторых авторов (Кудрявицкий, Куприянов, Онанов, Усачева и др.) процент выздоровления от отогенного менингита высокий, а у других более низкий. Анализ клинических наблюдений, приведенных указанными авторами, показывает, что речь идет о неосложненных формах менингита. Естественно, что лечение таких форм менингита, особенно при ранней его диагностике, дает в настоящее время весьма высокий процент выздоровления.
Читайте также:
- Лучевые признаки аутосомно-рецессивного поликистоза почек у плода
- Микробиологическая диагностика пневмококка. Диагностика пневмококковой инфекции. Выявление пневмококка. Выделение пневмококка. Лечение пневмококковой инфекции.
- Отравление железом и его побочные эффекты
- Лучевые признаки перибронхиального интерстициального фиброза (ПИФ)
- Лечение недостаточности кровообращения. Профилактика недостаточности кровообращения
